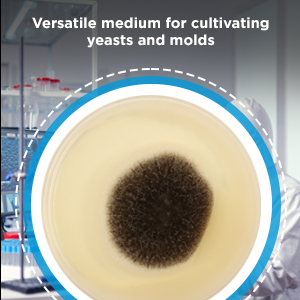
Small manufacture image 1

🍠 Cultivate Confidence with Every Culture!
TM MEDIA Potato Dextrose Agar 100gm is a premium, cream-to-yellow powder that forms a clear amber gel medium optimized at pH 5.6 ± 0.2. Recommended by APHA and FDA, it is designed for precise isolation and enumeration of yeasts and molds in dairy and food products, ensuring trusted lab results with a shelf life extending to 2029.

| ASIN | B0CKTJ7J6R |
| Brand | TM MEDIA |
| Country of Origin | India |
| Customer Reviews | 4.2 4.2 out of 5 stars (8) |
| Date First Available | 10 October 2023 |
| Generic Name | TM 344 |
| Importer | PG Micro Lab Solution LLP |
| Item Dimensions LxWxH | 15 x 15 x 15 Centimeters |
| Item Height | 15 Centimeters |
| Item Weight | 100 g |
| Item Width | 15 Centimeters |
| Item part number | TM 344_100gm |
| Manufacturer | Titan Biotech LImited, Titan Biotech Ltd |
| Net Quantity | 100.00 Grams |
| Number of Memory Sticks | 1 |
| Packer | PG Micro Lab Solution LLP |
| Product Dimensions | 15 x 15 x 15 cm; 100 g |
G**H
Validity upto 2029
Geninun... Validity upto 2029. Recommended
V**R
Good product
Good product for making pda culture. Go for it
ترست بايلوت
منذ 4 أيام
منذ يومين